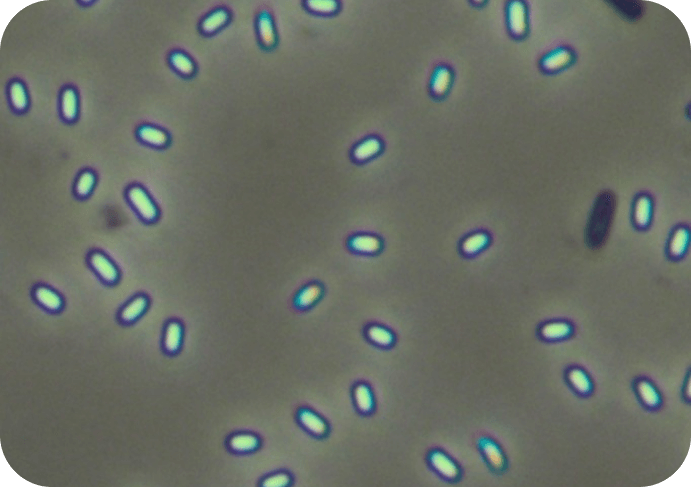
them

Unleash the power of unparalleled efficacy with Liquid Rhyno cutting-edge range of products.
From lightning-fast drain openers to revolutionary biological-patented formulations and high-performance cleaning solutions. Liquid Rhyno charges headfirst at household plumbing and cleaning needs with its hard charging muscle. Using the latest advancements in chemical and biological science to work swiftly and thoroughly, tackling even the toughest challenges with ease.
Why Liquid Rhyno?
Our company boasts a 100-year history dedicated to the research and development of specialty chemicals for commercial, institutional and industrial customers. We’ve taken the knowledge gained from industrial applications and tailored them for residential use. Now you can harness the power of professional-grade drain care, maintenance and cleaning.
We’ve developed products that not only clear clogs but also prevent future-build-up, keeping your pipes flowing smoothly month after month. Liquid Rhyno’s scientifically proven products, originally developed for tough plumbing issues have now been extended into versatile solutions for various cleaning needs throughout your home.


Their Enzyme Formula
Their enzyme-based products breakdown at initial use or are active only during initial application. These formulas do not continue to regenerate and create additional enzymes with frequent use continuously break down organic matter, eliminate odors at the root cause and reduce future build-up.
Our Bacteria Formula

Patented formula with 10 unique strands of bacteria and continuation of creating enzymes that are proven to break down what you find in your system and pipes. This is more than you will find than any other leading brand on the shelf.
Maintenance
Liquid Rhyno’s patented biological formulas boasts 10 unique strands of bacteria, surpassing other leading brands on the shelf. These active biologicals, present in every pod, powder, or liquid dose, create powerful enzymes specifically designed to break down organic matter in garbage disposals, drains, and pipes. Unlike some products that only offer enzymes for initial use or contain acids that inhibit bacterial activity, Liquid Rhyno’s bacteria continue to regenerate and produce enzymes over time. With regular application, these beneficial microorganisms multiply, continuously breaking down organic matter, eliminating odors at the source, and preventing future buildup. This ongoing enzymatic action sets Liquid Rhyno apart, offering a long-lasting solution for maintaining clean and odor-free plumbing systems.


Drain Care
Liquid Rhyno’s revolutionary formula removes clogs with 2X the concentrated power of leading bleach products, delivering unprecedented drain cleaning performance. This advanced solution cuts through standing water with remarkable efficiency, blasting away even the most stubborn blockages in residential plumbing systems.


Proudly Made in the U.S.A


